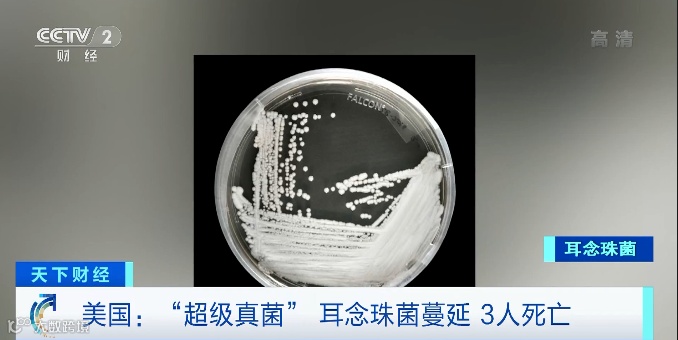

点击蓝字 关注我们

导读
新冠变种病毒来势汹汹,继印度之后,东南亚疫情也持续恶化。
泰国
泰国新冠疫情管理中心报告称,泰国单日新增新冠肺炎确诊病例首次超万例,达11397 例,单日新增死亡病例首次破百,达141例,新增确诊病例数和死亡病例数同时创新高。
△央视财经《天下财经》栏目视频

泰国政府宪报网站发布的公告显示,在全国范围内禁止公众集会,违者将面临最多两年监禁或4万泰铢(约合人民币7900元)的罚款,或两罚并处。
泰国总理巴育在同一天表示,政府还计划采取更多防疫措施,包括尽可能限制人员流动,关闭几乎所有非必要场所,以及要求民众居家办公等。
此外,泰国民航局 ( CAAT ) 在一份声明中表示,往返曼谷和泰国政府的列为 COVID-19 高风险省份的国内航班将从周三起暂停。医疗航班、紧急降落飞机和与政府旅游重新开放计划相关的航班除外,其他本地航班只能以 50% 的容量飞行。
与此同时,由于死亡病例不断增加,泰国许多医院正承受着前所未有的巨大压力,有的医院不得不租用集装箱充当临时的停尸房。


▲由集装箱改装的临时停尸房
另据美联社报道,泰国的疫苗接种工作目前进展缓慢,大约15%的人口接种了至少一剂疫苗。泰国卫生部门此前表示,准备对本土生产的阿斯利康疫苗施加出口限制,以确保先满足本国需求。
据越南卫生部近日公布越南新增2472例确诊病例,其中2454例是本土病例;18例是境外输入病例,入境后立即隔离。这两千多确诊病例中,仅胡志明市就有1756例。目前,越南全国新冠确诊病例累计51002例。

越南胡志明市成为疫情重灾区。目前,胡志明市感染总人数已超过26000人,占越南全国总感染人数的50%以上。
据悉,越南总理决定从7月19日0时开始,对越南南方16个省市实施“封城”,为期14天。加上正在“封城”的胡志明市、同奈省、平阳省,另外新增16个省市:芹苴、平福、西宁、巴地--头顿、前江、隆安、永隆、同塔、槟椥、后江、安江、薄辽、朔庄、茶荣、金瓯、坚江。
至此,越南共有19个省市“封城”,越南全境三分之一的国土被封锁,3500万人生活受影响。
此外,越南产能正遭受疫情的严重影响。鞋业龙头宝成、纺织大厂儒鸿受波及停工,西贡高科技园区也传出关闭,三星电子部分厂区暂停营运,多家机构发布报告示警,认为如果新兴市场不能在未来几个月控制住疫情,恐祸及当地经济复苏,加剧全球供应链挑战。

越南疫情对制鞋产业的冲击持续扩大,继宝成、百和之后,全球最大足球鞋制造商志强国际最近宣布配合越南政府防疫措施,旗下位于西宁省的志宁厂自17日起至30日止停工14天,并进行全厂清洁消毒。
据越南当地台商表示,除了宝成、百和、志强外,包括赐昌、中菲、清禄、德兴、福禄、乐意等制鞋大厂,也都配合政府要求,陆续采取暂时停工及清消措施。
尽管品牌客户订单畅旺,但各鞋厂不是被要求暂时停工,就是员工到工率低、产能降载,厂商也只能尽可能地弹性调度产能,加班赶工出货。
在此提醒,如最近有货发往泰国、越南,务必注意延误和把控收款风险。
在东南亚疫情失控的同时,英国、西班牙、法国等欧洲国家的疫情也卷土重来,美国感染人数飙升,疫情急剧恶化。
英国政府近日发布的数据显示,该国当天新增新冠确诊病例超5万例,达51870例,累计确诊5332371例;新增死亡病例49例,累计死亡128642例。英国单日新增新冠确诊病例数近期持续攀升!
西班牙也因为促进旅游等,不对英国的游客进行限制,单日增长了31060例。
根据法国卫生部门公布的数据,法国24小时新增新冠肺炎确诊病例再次超过1万例,达10908例,这是自5月29日以来单日新增病例首次超过1万例。
感染人数飙升,美国疫情有卷土重来之势。单日新增超7.4万例,创自4月中旬以来新高,并且是当天全世界最高纪录。
警惕!“超级真菌”正在美国蔓延!超百人感染
美国疾控中心官员近日表示,一种名叫耳念珠菌的真菌正在美国首都华盛顿特区和达拉斯这两个城市蔓延,目前已有超过百人感染,3人死亡。因具有超强耐药性,耳念珠菌被称为 “超级真菌”。
△央视财经《天下财经》栏目视频
据报道,耳念珠菌可以在人与人之间传播,今年1月起就开始在美国的医院中出现,并表现出抗药性。

今年1月至4月期间,华盛顿特区的一家疗养院和达拉斯地区的两家医院都报告了感染这种“超级真菌”的病例。其中,华盛顿特区的疗养院里有101人感染,其中3人被诊断出对治疗真菌的药物存在耐药性。达拉斯的两家医院共有22人感染,其中2人存在耐药性。目前,这5名患者中已有3人死亡。
美国疾控中心称,这种“超级真菌”对于免疫系统脆弱的人尤为危险,4月以来感染病例数仍在持续上升。

来源:浙江外贸



